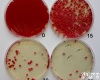
瓶、袋、箱、盒 Campy-Cefex <em>琼脂</em><em>培养基</em>基础<em>添加剂</em>
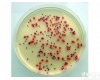
瓶、袋、箱、盒 改良 Campy-Cefex <em>琼脂</em><em>培养基</em>基础<em>添加剂</em>

Campy-Cefex 琼脂培养基基础添加剂
规格:2ml×10支/盒
用途:详见相关产品标签说明
英文名:详见相关产品标签信息
Campy-Cefex 琼脂培养基基础添加剂,规格:2ml×10支/盒,用途:详见相关产品标签说明,英文名:详见相关产品标签信息
兔血浆纤维蛋白原(RPF)琼脂培养基基础,规格:250g/瓶,用途:用于凝固酶阳性葡萄球菌检测,需添加兔血浆和YJ剂,英文名:RPF Agar Medium Base
酸性肉汤,规格:250g/瓶,用途:用于酸性罐头食品无菌检验,英文名:Acid Broth
EC肉汤(含倒管),规格:10ml×28支/盒,用途:详见相关产品标签说明,英文名:详见相关产品标签信息
杆菌肽,规格:20U×10支/盒,用途:培养基添加剂,英文名:Bacitracin
葡萄糖发酵管,规格:1ml*20支/盒,用途:用于细菌生化鉴定,英文名:详见相关产品标签信息
DNA酶试验琼脂,规格:100g/瓶,用途:用于核糖核酸酶检测,含0.2%DNA,英文名:Dnase Test Agar
木糖赖酸脱氧胆酸盐琼脂培养基(XLD),规格:250g/瓶,用途:用于肠道菌选择性分离,英文名:Xylose lysine Desoxycholate Agar
改良McBride琼脂基础(MMA),规格:250g/瓶,用途:用于李斯特氏菌的选择性分离,英文名:McBride Agar Base,Modified
无菌采样袋/均质袋(不带压条),规格:15cm×27cm,用途:用于样品采集、均质,英文名:详见相关产品标签信息
毛藓菌琼脂7号,规格:250g/瓶,用途:用于毛藓菌属的鉴定,英文名:Trichophyton Agar #7
M9肉汤,规格:250g/瓶,用途:——用于培养重组大肠杆菌菌株,英文名:M9 Broth
M9肉汤,规格:250g/瓶,用途:——用于培养重组大肠杆菌菌株,英文名:M9 Broth
碱性复红染色液,规格:5ml×4支/盒,用途:用于苏云金芽胞内蛋白质毒素结晶的染色,英文名:详见相关产品标签信息
0.5%纤维二糖发酵管,规格:1ml*20支/盒,用途:用于乳酸菌生化鉴定,英文名:详见相关产品标签信息
PPLO 肉汤基础,规格:250g/瓶,用途:无红,用于支原体的培养,英文名:PPLO Broth Base
PPLO 肉汤基础,规格:250g/瓶,用途:无红,用于支原体的培养,英文名:PPLO Broth Base
Wilkins-Chalgren厌氧菌肉汤,规格:250g/瓶,用途:用于厌氧菌的培养和药敏试验,英文名:Wilkins-Chalgren Anaerobe Broth
Grein – Meyers 琼脂,规格:250g/瓶,用途:用于链霉菌属的培养鉴定,英文名:Grein and Meyers Agar(Grein and Meyers, 1958)
牛心汤肉汤培养基,规格:250g/瓶,用途:用于链球菌增菌,英文名:Cattle Heart Broth Medium
TYCSB培养基基础,规格:500g/瓶,用途:用于变异链球菌的分离, 每100ml添加1支S0703,英文名:Tryptone Yeast Cystine Sucrose Bacitracin Medium
10%化胰酪胨大豆肉汤,规格:250g/瓶,用途:用于金黄色葡萄球菌的增菌和MPN试验,英文名:10% Sodium Chloride Tryptic Soy Broth
L-酪酸悬液,规格:5ml×10支/盒,用途:用于制备L-酪酸营养琼脂,每50ml营养琼脂添加1支,英文名:详见相关产品标签信息
DL-异亮酸,规格:1g/瓶,用途:详见相关产品标签说明,英文名:DL-Isoleucine
Kassanis 培养基,规格:500g/瓶,用途:详见相关产品标签说明,英文名:Kassanis Medium
嗜热脂肪杆菌恢复琼脂培养基,规格:250g/瓶,用途:用于灭菌与消毒鉴定试验,英文名:Bacillus Stearothermophilus Recovery Agar Medium
氧化酶试纸,规格:20片/盒,用途:用于细菌生化鉴定,英文名:详见相关产品标签信息
MRS培养基(改良MRS培养基基础),规格:1KG/瓶,用途:用于乳酸菌计数,改良MRS培养基每100ml需添加1支S1501,英文名:MRS Medium(Modified MRS Medium Base)
SB琼脂,规格:250g/瓶,用途:用于基因工程大肠杆菌的计数和培养,英文名:Super Broth Agar
Middle Brook 7H11琼脂基础/改良Middle Brook 7H11琼脂基础,规格:250g/瓶,用途:用于分枝杆菌分离培养,每180ml添加1支S0502和4支S1601,英文名:Middle Brook 7H11 Agar /Mitchison Modifi 7H11 Agar
酵母浸粉葡萄糖肉汤,规格:500g/瓶,用途:用于地衣芽孢杆菌、芽孢菌、密执安棍状杆菌、金黄杆菌、蜂房哈夫尼菌、荧光假单胞菌和粘质沙雷氏菌的培养,英文名:Yeast Extract Glucose Broth
链霉素溶液,规格:0.03g×20支/盒,用途:详见相关产品标签说明,英文名:详见相关产品标签信息
依姆歇涅茨基纤维素培养基,规格:250g/瓶,用途:用于好气性纤维素分解菌的测定,英文名:详见相关产品标签信息
SDALP,规格:55mm,用途:用于含洗必泰、季铵盐类消毒剂的物表监测,英文名:SDALP
蛋白胨山梨醇胆盐(PSB)肉汤,规格:250g/瓶,用途:用于耶尔森氏菌选择性增菌,英文名:Peptone Sorbitol Bile salts Broth
布鲁氏菌培养基基础,规格:250g/瓶,用途:每100ml添加5%血清以及1支S1901或S1902制备血清-葡萄糖-抗生素培养基,英文名:Brucella Medium Base
猪肺炎支原体培养基,规格:250g/瓶,用途:用于猪肺炎霉形体的培养,英文名:详见相关产品标签信息
YPGA培养基,规格:250g/瓶,用途:用于甘蔗流胶病菌检验,英文名:Yeast extract Peptone Glucose Medium
甘露醇盐琼脂,规格:250g/瓶,用途:用于金黄色葡萄球菌选择性分离(日本标准),英文名:Mannitol Salt Agar
MMN琼脂,规格:250g/瓶,用途:用于蜜环菌等外生菌根真菌的培养,英文名:Modified Melin-Norkrans Agar
温馨提示:不可用于临床ZL。